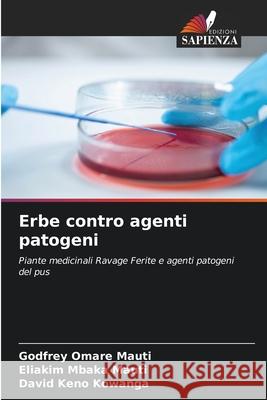
Erbe contro agenti patogeni Godfrey Omar Eliakim Mbaka Mauti David Keno Kowanga 9786206149538
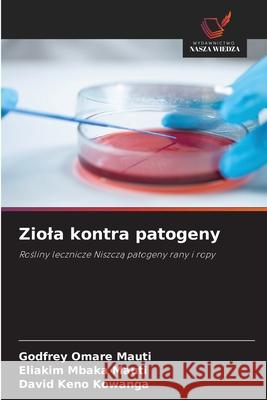
Ziola kontra patogeny Godfrey Omar Eliakim Mbaka Mauti David Keno Kowanga 9786206148654

Wyniki wyszukiwania:
wyszukanych pozycji: 15
 |
School Peer Review for Educational Improvement and Accountability: Theory, Practice and Policy Implications
ISBN: 9783030481322 / Angielski / Miękka / 2021 / 316 str. Termin realizacji zamówienia: ok. 16-18 dni roboczych. This book explores how peer reviews are used in school improvement, accountability and education system reform. Importantly, these issues are studied through numerous international cases and new empirical evidence. This volume also identifies and describes barriers and facilitators to the development, use, sustainability and expansion of school peer review. School peer reviews are a form of internal evaluation driven by schools themselves rather than externally imposed, such as with school inspections. Schools collaborate with other schools in networks, collect data through... This book explores how peer reviews are used in school improvement, accountability and education system reform. Importantly, these issues are studi... |
cena:
605,23 |
 |
Think Straight, Lose Weight: The revolutionary way to regain control and create the body you love
ISBN: 9781781332467 / Angielski / Miękka / 2017 / 244 str. Termin realizacji zamówienia: ok. 16-18 dni roboczych. You know how frustrating it can be when you have tried every diet imaginable, had countless expert opinions and still can't lose weight? If lasting weight loss were as easy as calories in vs calories out everyone would be skinny This book contains the missing link for achieving fast, easy and sustainable weight loss that nobody is talking about. - Condition your mind so that weight loss becomes inevitable - Build unstoppable motivation and self-confidence - Overcome self-doubt, self-sabotage and negative self-talk - Resolve binge eating and food... You know how frustrating it can be when you have tried every diet imaginable, had countless expert opinions and still can't lose weight? If l... |
cena:
81,96 |
 |
School Peer Review for Educational Improvement and Accountability: Theory, Practice and Policy Implications
ISBN: 9783030481292 / Angielski / Twarda / 2020 / 289 str. Termin realizacji zamówienia: ok. 16-18 dni roboczych. |
cena:
605,23 |
 |
An Ecosystem for Research-Engaged Schools: Reforming Education Through Research
ISBN: 9781138574465 / Angielski / Miękka / 2019 / 230 str. Termin realizacji zamówienia: ok. 16-18 dni roboczych. |
cena:
196,65 |
 |
An Ecosystem for Research-Engaged Schools: Reforming Education Through Research
ISBN: 9781138574458 / Angielski / Twarda / 2019 / 230 str. Termin realizacji zamówienia: ok. 16-18 dni roboczych. |
cena:
762,24 |
 |
Understanding the Newspaper Business in Nigeria: A Resource Book
ISBN: 9781443897730 / Twarda / 2016 / 150 str. Termin realizacji zamówienia: ok. 30 dni roboczych. |
cena:
238,07 |
 |
Policing the Factory: Theft, Private Policing and the Law in Modern England
ISBN: 9781472581709 / Angielski / Miękka / 2014 / 218 str. Termin realizacji zamówienia: ok. 30 dni roboczych. Policing the Factory describes the operation of the Bank of England police, the Post Office police, and various other private policing agencies, employed to track down and prosecute workplace offenders. The authors focus in particular on the Worsted Committee and their Inspectors, who, between 1777 and 1968, prosecuted thousands of workers in the north of England for taking home workplace scraps, or wasting their employer's time. Most of the workers prosecuted spent a month in prison upon conviction, and many more were dismissed from employment without any formal legal action taking... Policing the Factory describes the operation of the Bank of England police, the Post Office police, and various other private policing agenc... |
cena:
191,74 |
 |
Crime, Regulation and Control During the Blitz: Protecting the Population of Bombed Cities
ISBN: 9781350048522 / Angielski / Miękka / 2017 / 272 str. Termin realizacji zamówienia: ok. 30 dni roboczych. Crime, Regulation and Control during the Blitz looks at the social effect of bombing on urban centres like Liverpool, Coventry and London, critically examining how the wartime authorities struggled to regulate and control crime and offending during the Blitz. Focusing predominantly on Liverpool, it investigates how the authorities and citizens anticipated the aerial war, and how the State and local authorities proposed to contain and protect a population made unruly, potentially deviant and drawn into a new landscape of criminal regulation. Drawing on a range of contemporary sources, the book...
Crime, Regulation and Control during the Blitz looks at the social effect of bombing on urban centres like Liverpool, Coventry and London, critically ...
|
cena:
176,99 |
 |
Ervas versus Pat?genos
ISBN: 9786206144472 / Portugalski Termin realizacji zamówienia: ok. 10-14 dni roboczych. |
cena:
196,82 |
 |
Kr?uter gegen Krankheitserreger
ISBN: 9786206157717 / Niemiecki Termin realizacji zamówienia: ok. 10-14 dni roboczych. |
cena:
196,82 |
|
Erbe contro agenti patogeni
ISBN: 9786206149538 / Włoski Termin realizacji zamówienia: ok. 10-14 dni roboczych. |
cena:
196,82 |
|
Ziola kontra patogeny
ISBN: 9786206148654 / Polski Termin realizacji zamówienia: ok. 10-14 dni roboczych. |
cena:
196,82 |
 |
Les plantes médicinales contre les agents pathogènes
ISBN: 9786206150343 / Francuski / Miękka / 2026 / 52 str. Termin realizacji zamówienia: ok. 10-14 dni roboczych. La septicémie des plaies est un aspect très important des soins chirurgicaux. La connaissance des agents pathogènes bactériens associés aux plaies infectées est essentielle pour déterminer leur suppression et leur contrôle. Dans cet ouvrage, nous découvrons comment les plantes médicinales (ail Allium sativum, tulsi ; Ocimum sanctum bitter guard ; Momordica charantia et cannelle ; Cinnamomum verum), que l'on trouve localement sur les marchés et sous forme d'herbes, ont une activité antibactérienne et antagoniste contre les bactéries présentes dans les plaies et le pus.
La septicémie des plaies est un aspect très important des soins chirurgicaux. La connaissance des agents pathogènes bactériens associés aux plaie...
|
cena:
196,82 |
 |
Policing the Factory: Theft, Private Policing and the Law in Modern England
ISBN: 9781441107527 / Angielski / Twarda / 2013 / 224 str. Termin realizacji zamówienia: ok. 30 dni roboczych. Policing the Factory describes the operation of the Bank of England police, the Post Office police, and various other private policing agencies, employed to track down and prosecute workplace offenders. The authors focus in particular on the Worsted Committee and their Inspectors, who, between 1777 and 1968, prosecuted thousands of workers in the north of England for taking home workplace scraps, or wasting their employer's time. Most of the workers prosecuted spent a month in prison upon conviction, and many more were dismissed from employment without any formal legal action taking...
Policing the Factory describes the operation of the Bank of England police, the Post Office police, and various other private policing agencies...
|
cena:
688,47 |
 |
Soul of a Nation: Art in the Age of Black Power
ISBN: 9781942884170 / Angielski / Twarda / 2017 / 256 str. Termin realizacji zamówienia: ok. 16-18 dni roboczych. African American art in the era of Malcolm X and the Black Panthers In the period of radical change that was 1963-83, young black artists at the beginning of their careers confronted difficult questions about art, politics and racial identity. How to make art that would stand as innovative, original, formally and materially complex, while also making work that reflected their concerns and experience as black Americans? Soul of a Nation surveys this crucial period in American art history, bringing to light previously neglected histories of 20th-century... African American art in the era of Malcolm X and the Black Panthers In the period of radical change that was 1963-83, young ... |
cena:
192,68 |










